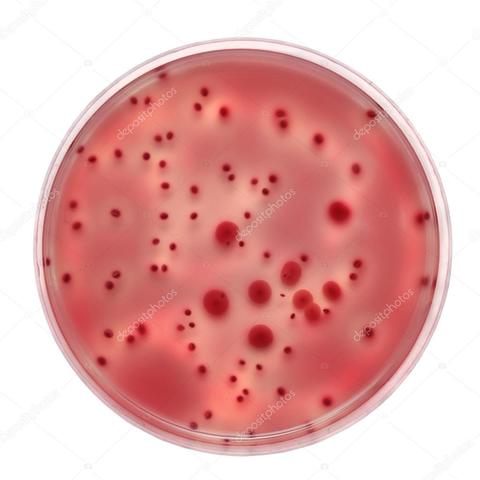
Experimento de Needham e Spallanzani

-
Diversas maneiras que produziam arte antigamente , como a arte era valorizada ,quando começou a surgir,para o que usavam-se a arte,etc
-
A idade antiga foi o período que abrange os pré Socráticos Herácleto,Tales,Demócrito,Parmenidês .E os principais filósofos que foram Sócrates, Platão e Aristóteles que criaram conceitos como ética,Maiêutica,teoria das ideias e etc...
-
A matemática surgiu há muito tempo atrás quando os homens sentiram a necessidade de contar.E até hoje ela emprega um papel muito importante, pois para quase tudo ela é utilizada.
-
O alemão surgiu com os antepassados alemães na península dinamarquesa , temos três tipos alto alemão , baixo alemão , e alemão padrão.Atualmente 14,5 milhões falam alemão.
-
teoria sobre o surgimento da vida
-
A Idade Média foi um longo período da história que se estendeu do século V ao século XV. Seu início foi marcado pela queda do Império Romano do Ocidente, em 476, e o fim, pela tomada de Constantinopla pelos turcos em 1453.Na filosofia temos o período helenístico que abrange o cinismo,ceticismo,epicurismo e estoicismo;e a igreja católica com grande influencia,entre outras características...
-
A história do espanhol começou há muitos séculos atrás. O espanhol é um idioma latim com fortes influências árabes e inclusive germânicas. O idioma começou a nascer no século III a.C. com a chamada romanização da Península Ibérica e a implantação do latim como idioma oficia.
-
A Idade Moderna é o momento da história do século XV até XVIII e que está localizado temporalmente entre a Idade Média e a Idade Contemporânea.O que marca o início é a queda de Constantinopla em Roma.A idade moderna é caracterizada por ser matematizada,lógica e racional.Como filósofos temos Kant com a teoria copernicana ,S. Locke,Descarte...
-
Aprovação que a teoria da abiogênese era falsa
-
meio de cultura (bactérias e micro-organismo)
-
A idade contemporânea foi marcada por grandes revoluções,guerras e pelos avanços tecnológicos.Um marco foi a escola de Frankfurt que está relacionada a cultura de massa, industria cultural e estética.Uma característica é o fim não determinado.
-
A Teoria dos Conjuntos foi criada e desenvolvida pelo Matemático russo George Cantor (1845-1918), trata-se do estudo das propriedades dos conjuntos, relações entre conjuntos e relações entre os elementos e o próprio conjunto.
-
Teoria da biogênese,acreditava-se que o ser vivo se originava de outro ser vivo .
-
Foi um sociólogo, que acreditou na possibilidade da interpretação da sociedade partindo de fatos sociais já consolidados e suas características externas.Criou diversos conceitos entre eles tipos de ação social, relação social e pensamentos sobre o sistema capitalista e mundo moderno.
-
Hitler nasceu no dia 20 de abril de 1889, na localidade de austríaca de Braunaun Am Inn. Foi filho de um funcionário da alfândega e passou sua infância em Linz.Seu marco maior foi a liderança do nazismo (nacional-socialista).
-
Durkheim nasceu em 1858 na França ,filho de Judeus foi um dos pioneiros da sociologia.O pensador criou diversos conceitos, entre eles o de suicídio.Em seus estudos concluiu há existência de três tipo:egoísta,altruísta e anômico.Altruísta é quando alguém morre por amor pela sua sociedade como por exemplo em uma guerra.Egoísta é um suicídio por frustação. Já no suicídio anômico acontece por mudanças sociais, quando a pessoa perde seus objetivos e identidade.
-
Como surgiu geografia ,como era usada antigamente ,etc..
-
O positivismo é uma corrente filosófica que surgiu na França no início do século XIX. Ela defende a ideia de que o conhecimento científico seria a única forma de conhecimento verdadeiro.
-
Vênus de Willendorf, hoje também conhecida como Mulher de Willendorf, é uma escultura de 11,1 cm de altura representando estilisticamente uma mulher. Essa pequena escultura foi descoberta pelo arqueólogo Josef Szombathy em 8 de agosto de 1908, durante as escavações realizadas no sítio arqueológico do período Paleolítico, localizado próximo à Willendorf, Áustria e sua datação está entre 25.000 a 20.000 a.C.
-
Teve duas fases , e a primeira tentativa de implantar sociedade socialista ...
-
Causas: Imperalismo,nacionalismo,aliança militares,rivalidades...
-
Ascensão Regime totalitario
-
A Grande Depressão, também conhecida como Crise de 1929, foi uma grande depressão econômica que teve início em 1929, e que persistiu ao longo da década de 1930, terminando apenas com a Segunda Guerra Mundial. A Grande Depressão é considerada o pior e o mais longo período de recessão econômica do século XX.
-
Teoria que conclui que a vida se originou da evolução molecular
-
A Guerra Civil Espanhola foi um conflito de forças políticas pela disputa do poder na Espanha. Foi liderada pelo generalíssimo Francisco Franco, que abalou a Europa, entre os anos de 1936 e 1939.
-
Resultado de imagem para guerra fria resumo
A Guerra Fria foi uma disputa pela superioridade mundial entre Estados Unidos e União Soviética após a Segunda Guerra Mundial (1939-1945). É chamada de Guerra Fria por ser uma intensa guerra econômica, diplomática e ideológica travada pela conquista de zonas de influência. -
Teoria cientifica que explica a origem de tudo
-
Criação do Estado de Israel
Looking for a timeline maker?
Create timelines for projects, roadmaps, history, lessons, legal cases, and stories with Timetoast. Timetoast is a timeline maker for work, school, research, and stories.